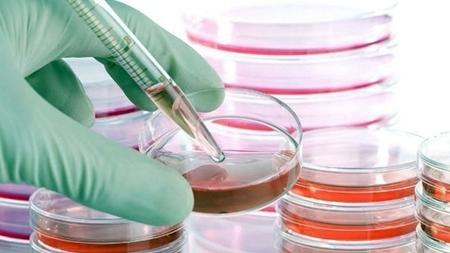

محصول ایرانساخت به کاهش یک عارضه پوستی کمک کرد
به گزارش خبرگزاری مهر به نقل از معاونت علمی و فناوری، محمد حسین زیرک ساز مدیرعامل یک شرکت دانشبنیان با بیان اینکه ریکالرسل یکی از محصولات دانشبنیان این شرکت است، گفت: محصول ریکالرسل بهصورت سوسپانسیون سلولی است و روش استفاده آن تزریق داخل اپیدرمال در لکههای حاصل از بیماری ویتیلیگو یا لکوپیس است.
وی افزود: ویتیلیگو زمانی رخ میدهد که سلولهای تولیدکننده رنگدانه از بین بروند و یا تولید ملانین را متوقف کنند. ازآنجاکه مشکل اصلی بیماران ویتیلیگو، ناکارآمد بودن سلولهای تولیدکننده ملانوسیت است، این محصول به درمان بیماری ویتیلیگو با پیوند خودی سلولهای ملانوسیت که یک روش سلول درمانی محسوب میشود، کمک میکند. نتایج این شیوه درمانی جدید روی مبتلایان به لکوپیس کاملاً بیخطر و بسیار رضایتبخش بوده است.
زیرک ادامه داد: این محصول یک فرآورده سلولی است که حاصل جداسازی سلولهای کراتینوسیت و ملانوسیت در شرایط استریل بوده و ساختار شیمیایی تعریف شدهای ندارد. این محصول حاوی سلولهای زنده کراتینوسیت و ملانوسیت کشت نشده مشتق از لایه اپیدرم پوست خود بیمار است. سلولهای کراتینوسیت قابلیت تحریک رنگدانه سازی داشته و سلولهای ملانوسیت قادر به تولید ملانین هستند.
به گفته مدیر شرکت، برای تولید این محصول ابتدا از بیمار نمونه پوست کم ضخامت از ناحیه نشیمنگاه بیمار گرفته شده و سپس جداسازی سلولهای کراتینوسیت و ملانوسیت با استفاده از روشهای آنزیمی صورت میگیرد و سلولها ۲۴ ساعت بعد از نمونهبرداری در نواحی تعیین شده پیوند میشوند.
وی با بیان اینکه دانش فنی این محصول کاملاً بومی است و مشابه خارجی قابل قیاسی ندارد گفت: این محصول از سال ۱۳۹۸ به تولید تجاری رسیده است و در حال حاضر در این شرکت ۵۰ نفر مشغول به فعالیت هستند.
زیرک خاطر نشان کرد: از دیگر محصولات دانشبنیان این شرکت میتوان به مزستروسل که برای درمان آرتروز زانو است اشاره کرد.
"این محصول حاوی سلولهای زنده کراتینوسیت و ملانوسیت کشت نشده مشتق از لایه اپیدرم پوست خود بیمار است"آرتروز شایعترین بیماری التهاب مفاصل است که بیش از نیمی از جمعیت بالای ۶۰ سال را درگیر کرده است. سلول درمانی بیخطرترین و مطمئنترین روش درمانی محسوب میشود. رنیودرم سل برای چینوچروک صورت و بانک سلولی وارتو سل نیز از محصولات دیگر این شرکت هستند.
اخبار مرتبط
دیگر اخبار این روز
حق کپی © ۲۰۰۱-۲۰۲۶ - Sarkhat.com - درباره سرخط - آرشیو اخبار - جدول لیگ برتر ایران